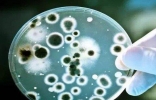

大量的糖进入到身体会超出身体的需求,除了会转变成脂肪,也有可能会导致血糖偏高的情况加重,所以我们应该要适当的吃一些含糖量比较低的水果,那么,大家知道低糖水果有哪些?今天世界之最网小编为大家列出十大低糖 ...
2022-5-30 22:54

水果大家都酷爱吃,各种水果的营养价值都是不一样的,能补充人体所需的营养,那你知道营养价值比较高的水果有哪些?今天世界之最网小编为大家列出水果排行榜前十名,让我们一起来详细了解一下吧。水果排行榜前十名1 ...
2022-5-30 22:54

水果以丰富的营养价值,酸甜可口的味道,成为备受人们喜爱的食物之一。水果好吃的同时还具有丰富的营养,世界上的水果品种多种多样,那你知道公认最好吃的水果有哪些吗?今天世界之最网小编为大家列出公认最好吃的水 ...
2022-5-30 22:53

孕妇缺血是很严重的一件事情,因为可能就会导致胎儿供血不足,或者是对自身健康带来一定的危害。因此补血十分关键,最好的办法就是通过服用水果。那你知道孕妇贫血吃什么水果补血?今天巴拉排行榜网小编给大家推荐孕 ...
2022-4-19 20:50

每天适当吃些水果,对身体的健康非常有好处,但是吃水果也要掌握最佳的时间,有时吃水果的时间不合适,反而容易导致肠胃负担,都说晚上的时候,吃水果容易导致肠胃负担,还容易发胖,下面我们来了解一下吃水果的最佳 ...
2022-4-13 18:22

孕妇在怀孕期间需要摄取各种营养,这对腹中胎儿的发育非常重要,在新鲜水果里面摄取营养是一个很好的选择,平时一定要多吃水果和蔬菜,尤其是富含蛋白质和铁的水果,但是也不是所有的水果都适合孕妇吃,一起看看孕妇 ...
2022-3-23 11:24

由于目前交通日趋便利,世界变得更小,同时各类催生、膨胀类果营养素的过量使用,使得我们可以几乎在任意时节吃到任意想吃的水果。那么,究竟哪些水果才是当季时令盛产的,哪些是这个时候吃最适合的,下面由未解之谜 ...
2022-3-21 15:56

水果富含营养,生活中常见的水果不用多说,世界上最吓人的水果你有听说过吗? 死人手指 死人手指实际上是野香蕉,也就是八月瓜,这种水果不仅可以食用,味道还相当不错,但是外貌着实有点可怕,很多人看着有点闻风 ...
2022-2-21 21:52

在我们平时的生活中,有很多的水果和减肥会有非常大的联系。水果具有低热量、高营养的特点,也是广大减肥群众最喜爱的代餐食物,不仅可以达到减肥效果,还可以补充人体所需要的营养物质。那么你知道吃什么水果减肥? ...
2022-1-19 19:36

众所周知,水果中都含有非常丰富的营养成分,日常生活中多吃水果、蔬菜是健康养生保健中的主要内容。而巧吃水果还可以帮助提高免疫力,减少疾病的困扰。那么,你知道究竟吃什么水果可以提高免疫力呢?今天巴拉排 ...
2022-1-7 21:37

水果是我们经常吃的食物,水果不仅营养丰富,热量极低,还能解腻,是开胃消暑的必备美食。可是有些水果,别说吃过,有的人一辈子都没见过,这些就是世界上最奢侈的水果,现在巴拉排行榜网小编为大家介绍世界上最 ...
2022-1-3 21:39

水果以丰富的营养价值和多种多样的可口的味道,成为人们生活中不可或缺的食物之一。全世界的水果品种是数不胜数,很多咱们几乎都未曾听过。那么,你知道哪些水果是国内最受欢迎的呢?今天巴拉排行榜网小编就带大 ...
2022-1-1 21:47

新疆,位于我国的西北部,是我国最大的一个省份。新疆是个好地方,水草丰美,物产丰富,有很多的特产,那你知道新疆有哪些著名的水果?下面巴拉排行榜网就给各位介绍下新疆十大特产水果,快来了解一下吧。 新疆 ...
2021-12-12 20:25

猕猴桃是一种常见的水果,吃了对身体有好处。有人想问猕猴桃是热性的水果还是凉性的水果,比较适合什么人群吃呢,下面一起了解下吧。 猕猴桃是热性还是凉性 杀死癌细胞最狠的水果 猕猴桃是一种凉性水果,虽然是杀死 ...
2021-12-9 21:30

女性每个月都会经历经期这个阶段,而在这期间,女性很容易出现内分泌失调、痛经等问题,也有很多需要忌口的地方。那么,你知道经期不能吃的水果有哪些吗?下面是生理期忌口的十大水果排名,一起来看看。10.椰子椰子 ...
2020-5-6 12:49

秋季是丰收的季节,很多果实也是在秋季成熟。水果口感好,营养丰富,可以为人体提供维生素等营养元素,补充人体所需要的养分。那么,你知道秋天的水果有哪些吗?下面小编为大家带来秋季十大时令水果盘点,一起来看看 ...
2020-5-6 12:49

血糖高通常会导致人体调节功能发生紊乱,还容易引发糖尿病。因此,存在血糖高的人群在饮食上需要额外注意,糖分高的食物千万要少吃,还要尽量多吃一些具有降血糖功效的食物。接下来,小编为大家带来了十种降糖水果排 ...
2020-5-6 12:48

也许你喝过猫屎咖啡,但是你肯定没有吃过猫屎瓜,这被成为世界上最奇葩的水果猫屎瓜,可不是从猫拉的屎中找出来的瓜果,而是真正的猫屎,而且还是可以直接吃的。实际上是一种长得非常像猫屎的一种瓜果,虽然长得 ...
2020-4-26 22:47
苹果是我们日常生活中不可或缺的美味水果,每个人都知道吃前应该仔细清洗。但你知道吗,除了纤维、黄酮类化合物外,每个苹果携带的细菌高达1亿个。这是好事吗?可能如此,但这可能取决于苹果是如何培育的。 ...
2019-9-26 10:09

水果是人们生活中不可或缺的食物,它们含有丰富的营养成分,可以给人体补充日常所需的维生素和其他营养物质。即便它们富有营养,但并不是每一种水果都好吃,有的甚至可以说相当的难吃。今天小编就为大家整理出了世界 ...
2019-8-19 17:04